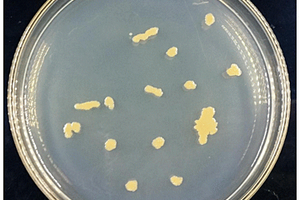
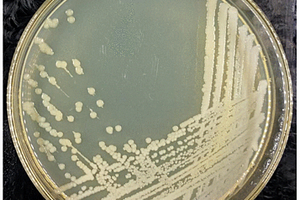

全部
898
898
 0
0
本发明公开了一种红霉素降解菌IURM F69及其应用,属于生物技术领域,本发明提供的红霉素降解菌及其应用,通过微生物筛选处理技术,即根据红霉素的理化性质,在特定环境条件中筛选或者通过改造,得到能够降解红霉素的微生物,以大环内酯酶,转移酶,裂解酶等酶类对红霉素结构进行破坏,得到极小危害的代谢产物,从而达到红霉素无害化处理的目的,实验证明,本发明的红霉素降解菌IURM F69能在仅以红霉素为碳源的特殊环境中存活,达到48%‑67%的降解效率,相关酶降解红霉素的活性高,本发明所提供的红霉素降解菌IURM F69可以应用于污染环境中的红霉素降解,在菌渣固废处理和水污染处理方面具有很好的应用价值。
943
943
 0
0
本发明公开了一种红霉素降解菌IURM F57及其应用,属于生物技术领域,本发明通过微生物筛选富集,根据红霉素的理化性质,在特定环境条件中筛选得到能够降解红霉素的微生物,以大环内酯酶,转移酶,糖苷酶等酶类对红霉素结构进行破坏,得到危害小,无污染的代谢产物,从而达到红霉素无害化处理的目的,实验证明,本发明的红霉素降解菌IURM F57能在仅存在红霉素为碳源的特殊环境中存活,红霉素降解率达到54‑69%的,本发明所提供的红霉素降解菌IURM F57可以应用于药企菌渣废物与污染环境中的红霉素降解,在菌渣固废处理和水污染处理方面拥有良好的实际应用价值。

 1163
1163
 0
0
本发明提供一种刮板式低温蒸发器,包括蒸发器本体与抽真空装置;所述蒸发器本体包括蒸发器筒体;所述蒸发器筒体包括相互贯通的上筒体与下筒体;所述上筒体内部设置有冷凝装置,以及冷凝水收集结构;所述上筒体的外壁上设置有冷凝液出口,所述冷凝液出口与所述冷凝水收集结构相通;所述冷凝液出口与所述抽真空装置相连;所述下筒体的外部设置有夹套;所述下筒体的底部设置有进料口与出料口。本发明提供的刮板式低温蒸发器,通过减速电机与抽真空装置相配合,使得本申请提供的刮板式低温蒸发器能够将物料浓缩为泥浆状物质甚至固废来直接排放,不仅提高了对物料的浓缩度,还可以降低企业的委外费用,降低生产成本。

 1060
1060
 0
0
本实用新型公开了一种移动式垃圾处理方舱装置,其包括固废粉碎方舱、焚烧方舱和烟气净化方舱,固废粉碎方舱包括第一舱体、安装在第一舱体内的破碎机和燃油箱;焚烧方舱包括第二舱体,在第二舱体内安装有焚烧炉,该燃油箱的供油口经进油管连通焚烧炉的进油口;烟气净化方舱包括第三舱体,在第三舱体内安装有喷淋箱、布袋除尘器、烟气风机和空压机,焚烧炉的烟气出口经喷淋箱连通布袋除尘器,烟气风机连通布袋除尘器;该空压机的空压出口连通布袋除尘器。整个装置分为三个方舱,以便于分散运输到需要的地点,然后再进行组装。本申请可以对应急抢险救灾过程中所产生的垃圾进行焚烧处理,焚烧后所生产的烟气经过烟气净化方舱处理后进行达标排放。

 1143
1143
 0
0
本发明公开了一种再生轻质底层抹灰石膏砂浆,配方包括如下重量份:脱硫石膏500‑800份、水泥10‑30份、再生机制砂收尘粉50‑400份、再生装修垃圾磨粉料50‑300份、玻化微珠40‑80份、石膏缓凝剂0.5‑2.0份、石膏减水剂0.2‑1.0份、纤维素醚1.0‑2.5份、淀粉醚0.5‑2.0份、木质纤维0.2‑1.0份、PP纤维0.2‑1.0份、引气剂0.03‑0.12份、水400‑650份。该砂浆重量轻,可有效的降低建筑物的承载重量,涂布面积大,而且使用了再生机制砂收尘粉、再生装修垃圾磨粉料建筑固废处理物,有效的实现了建筑固废的资源化利用,绿色环保,具有很好的市场前景。

 902
902
 0
0
一种高级氧化快速修复土壤污染的技术装置。本发明以电化学为基础在催化材料上加以进行改性,以水为介质在外加电场下氧化性物质浓度得到最大化的提高,通过所激发出的新生态势的氧化性物质对土壤稀释后所含的有机污染物进行快速强氧化分解。采用该技术能够对重污染行业企业、工业遗留场地、固废堆放及处理处置场地的土壤中的有机污染物的去除率达到95%以上。

 896
896
 0
0
本发明提供了一种生活污泥焚烧烟气的处理系统,其能解决后续飞灰处置成本高的技术问题。一种生活污泥焚烧烟气的处理系统,其特征在于:包括依次连接的急冷塔、脱酸塔、第一布袋除尘器和第二布袋除尘器,第一布袋除尘器和第二布袋除尘器相连的管道上连接有活性炭投加装置。该系统处理烟气时,通过对第一布袋除尘器收集的飞灰进行抽样检测,若是一般固废,则按一般固废进行处置,若是危废,则和第二布袋除尘器的含活性炭的危废合并处置,能够有效减少危废总量,降低处置成本。

 783
783
 0
0
本发明公开了一种新型轻质高强砂基透水砖及其制备方法,该透水砖按质量计由地聚物水泥100份、增强剂5~12份、增稠剂1~10份、高强陶砂350~650份、速凝剂1.5~3.5份、着色剂3~5份、减水剂0.5~3.0份和水15~20份组成,通过在搅拌机或混料机中多次充分混合搅拌后,置于制砖机中振动成型。本发明利用了钢渣、粉煤灰等大宗固废,解决了现有透水砖孔隙易堵塞、透水时效不佳、密度大的不足。本发明制备的透水砖的透水性能好、透水时效长、抗压强度高、密度较小,可广泛用于海绵城市等市政工程建设,提高了钢渣等大宗固废的利用附加值,保护了生态环境。

 1018
1018
 0
0
本实用新型公开一种厨余垃圾处理器,包括壳体,进料口下方刀片、第一过滤网、透光进料漏斗,透光进料漏斗中心的转轴上设有螺旋刀片,螺旋刀片下方设有第二过滤网,第二过滤网靠近壳体侧的下方设有上烘干板,上烘干板呈倒扣漏斗型,壳体内壁设置紫外线杀菌灯,第二过滤网下方靠近转轴上设有滤水板,下烘干板的上方设有湿度传感器,滤水板的下方设有净水箱、净水网板,本装置能够做到固液分离处理厨余垃圾,并且采用紫外线杀菌灯及上下烘干板能够杀菌消毒,使得参与固体垃圾保持干燥,干净卫生,同时净水装置可以对厨余废水进行过滤,便于后续排放,装置设有防倾倒支架能够保持平稳,设有万向轮方便移动,应用方便。

 727
727
 0
0
本实用新型公开了防溅水的医用洗手池,包括有洗手池本体,所述洗手池本体的顶部固定连接有顶板,所述顶板的顶部设置有三个水龙头,所述洗手池本体内腔底部的前后两侧均固定连接有放置板,所述洗手池本体内腔的底部安装有三角海绵板,所述洗手池本体正面的一侧固定连接有固定壳,所述固定壳的内部固定连接有过滤板,所述洗手池本体正面的一侧与固定壳背面上方的连接处开设有进料槽,本实用新型通过三角海绵板的设置可以避免水外溅,从而导致出现交叉感染的情况,通过固定壳、进水孔、进料槽和过滤板之间的配合可以实现对固体杂质和清水的分离,有效实现对废水的分开处理,避免出现堵塞的情况。

 1181
1181
 0
0
一种垃圾处理用塑料袋分类装置,包括支撑板,所述支撑板的底部对称安装有支腿,所述支撑板的顶部通过支架转动连接有筛板,所述筛板的底部一端安装有震荡装置,所述支撑板的顶部靠近震荡装置的一端固定连接有竖板,所述竖板的顶部安装有震荡摆锤,所述支撑板的顶部位于筛板的下方开设有掉落孔,所述支撑板的顶部远离震荡装置的一端安装有风机,所述支撑板的底部安装有推料装置,本实用新型涉及垃圾处理设备技术领域。本实用新型解决了现有的垃圾分类装置筛分板容易堵塞,降低垃圾筛分的效率,需要经常对筛分板进行清理,增加了垃圾分类的成本,同时垃圾筛分后固体废料体积较重不方便转移的问题。

 960
960
 0
0
本实用新型属于化工危化品和冶金行业的操作领域,具体涉及一种焦油渣后处理系统。一种焦油渣后处理系统,其包括一种用于焦油渣存储和液化的液化罐,还包括与液化罐的出料口连接的研磨组件,研磨组件用于对焦油渣的固体颗粒进行破碎,研磨组件连接有输送组件,输送组件将破碎后的焦油渣输送到分离装置中,分离装置通过离心力对焦油和干渣进行分离。本实用新型设计了一种具有研磨组件的焦油渣后处理系统,通过研磨系统对油类物料中的颗粒、团聚结晶、粉块粉团等颗粒物进行剪切破碎,使得油类物料中的颗粒物细化,同时也可以将颗粒物中的焦油充分的释放出来,从而提高分离效果,真正做到变废为宝,实现循环经济的发展路径。

本发明公开了一种制备反式-4-(叔丁氧羰基氨基)环己甲酸中间体异构化的方法,采取成盐工序、异构化、中和、后处理工序,使制备出的反式-4-氨基环己烷甲酸纯度高达98%以上。本发明具有以下优点1)副反应少,制得的产物反式纯度高,反式异构体纯度从25%大幅提高至98%;2)用水做溶剂,代替文献报道的高沸点溶剂,更加绿色环保;3)催化碱用量少、能够回收套用,产生的固废少,污染少,适合工业化生产。

 888
888
 0
0
本实用新型属于等离子净化技术领域,具体的说是等离子净化装置,包括本体;所述本体的一端设有进气部;所述本体的另一端设有出气部;所述本体内部靠近进气部一侧的顶端和底端均开设有滑槽;所述滑槽内远离进气部的一端均固接有第一弹簧;所述第一弹簧的另一端均固接有滑块;两个所述滑块之间共同固接有HEPA过滤网;两个所述连接杆相靠近一端之间共同固接有连接管;所述连接管的内部设有推送杆;所述推送杆靠近出气部的一端固接有连接块;所述连接块的另一侧的顶端和底端均固接有呈倾斜状态的敲打杆;进而该装置能够对等离子净化器内部的HEPA过滤网进行清理,避免出现HEPA过滤网受到固体颗粒堵塞,从而影响废气进入等离子净化器的情况发生。

 949
949
 0
0
本实用新型公开了一种分散式具有智能控制的有机垃圾处理设备,包括柜体和电控箱,在矩形箱的一侧固定安装竖向设置的电控箱,在柜体前端面的一侧沿高度开设有矩形的安装槽,在安装槽内固定安装有电动提升机,在柜体顶端的一侧固定安装有漏斗状的进料口,在柜体顶端的另一侧开设有矩形的入料口;在控制面板的中部设置有PLC液晶显示屏;在电控箱内的底部设置有驱动组件,在电控箱内的顶部设置有控制组件;本实用性新型结构简单,通过搅拌组件的螺旋式搅拌叶的转动将添加带有微生物的载体填料于固体废渣正反搅拌,确保两者之间的充分融合;整体处理过程绿色环保,可电控自动化,不仅增加资源利用率而且减少对于生态环境的污染。

 1144
1144
 0
0
一种高聚物耐油耐高温性能的环保型板材,其特征是其原料由以下重量份的成分组成:电厂废渣30-35份、沥青20-30份、氯化聚氯乙烯树脂35-45份等。本发明以高炉钢渣、粉煤灰及脱硫石膏等工业固废和水泥为主要原料,并配入硅灰石粉和消石灰粉,产品具不仅能减小工业固废排放对环境的污染,隔热保温,还能起到变废为宝的经济和社会效益。可以有效抵御成膜后低温脆裂,高温流淌等缺点,同时具有弹性回复率较高,稳定性好以及储存时间长、耐火阻燃等优点。本发明添加的聚氨酯弹性体具有优异的耐磨、耐油性能,且属于极性聚合物能和聚丙烯有机结合为一体,可有效提高聚丙烯电缆料的力学性能;加入的氟橡胶具有耐高温、耐油等特性,加入的其他填料可以增强电缆的其他物理性能和加工性能。

 1226
1226
 0
0
本实用新型涉及废水处理设备,具体地说,是一种自清洗排污过滤器。主要包括过滤头,所述过滤头为三个依次排列,上下方分别都连接至水管,所述过滤头下方连接反冲洗阀组件,所述组件一端设有反冲洗阀,另一端设有排污口,并且下方连接至水管,所述水管下方设有基座,另一端为进水口,所述过滤头上方水管设有出水口与排气阀以及压力表。采用了完全靠滤液压力提供自清洗动力,在运行过程中无须停下来清洗过滤元件,整体体积较小,精度可调节,适用于低粘度液体中固体物质的过滤,并且能够精确过滤、高效反洗、运行可靠、维护简单、使用寿命长,过滤效率有很大提高,同时也大大节省了制造成本,具有一定的经济效益。

 1108
1108
 0
0
本发明涉及一种液体除氟剂的生产方法,具体涉及一种利用废盐酸、含铝污泥制备高效除氟剂的新方法,属于环境化工、废水处理技术领域。其特点是利用工业副产废盐酸、碳酸钙、铝制品行业含铝污泥为主要原料,先后按一定比例进行反应,以氢氧化钙调整pH,加入稳定剂后,常压聚合得到无色至淡黄色液体。本发明将生产废物“无害化”和“资源化”,变废为宝;生产过程达到“零排放”,所得产品质量稳定;本发明设备简易,生产成本低,易于推广;经生产检验,可有效降低生产成本,使工业废酸、含铝固废得到综合利用,经济和社会效益显著。

 776
776
 0
0
本实用新型公开了一种干法预处理地沟油的设备,包括依次设置的一级原料罐、电絮凝槽、压滤泵、袋式压滤机和二级原料罐,以及将前述各部件连通的管道本实用新型采用电絮凝槽法处理原料,除产生少量的固体杂质以外,没有其他废弃物产生,因此绿色环保,并且污染很小。

 1040
1040
 0
0
本实用新型涉及一种羧甲基纤维素钠工业污水处理装置,包括过滤设备、一效蒸发器、二效蒸发器、至少一个用于沉降固液分离的母液槽和离心机,过滤设备的污水进口连接集水池的污水出口,过滤设备的污水出口连接一效蒸发器的污水进口,一效蒸发器的污泥出口连接母液槽的污泥进口,一效蒸发器的污水出口连接二效蒸发器的污水进口,二效蒸发器的污泥出口连接母液槽的污泥进口,母液槽的污水出口连接二效蒸发器的污水进口,母液槽的污泥出口连接离心机。本实用新型对废液进行多道蒸发浓缩,效率高,能耗低,得到浓缩的可用的固体盐份,实现资源化综合利用,同时实现污水零排放。

本实用新型公开了一种带有吹扫功能的丙烯酸酯过滤装置及包含它的丙烯酸酯净化装置。带有吹扫功能的丙烯酸酯过滤装置,包括空气压缩机、换热器、热源储罐、冷料收集罐、成品罐、气动隔膜泵和膜过滤器;成品罐、气动隔膜泵、膜过滤器和成品罐通过管路依次连通、形成循环;换热器上的进气口与空气压缩机连通,换热器上的出气口通过管路和成品罐与气动隔膜泵之间的管路连通;换热器上的热源进口与热源储罐连通,换热器上的热源出口与冷料收集罐连通。本实用新型通过加热后的压缩空气对膜过滤器进行吹扫,不仅减免了物料的损失,且减少了固体废气物产生,从而避免了环境的污染;降低了过滤膜更换的操作难度,降低了员工的劳动强度,提高了工作效率。

 1128
1128
 0
0
本实用新型属于固体废弃物分离设备的技术领域,涉及一种可防止容器晃动的翻转振荡器,其包括翻转盒,所述翻转盒包括盒体和盒盖,且盒体底面开设有若干容纳槽,还包括设置在盒盖下表面的限位板,所述限位板与盒盖平行,限位板上穿设有螺杆,限位板与螺杆螺纹配合,所述螺杆垂直于盒盖设置,螺杆穿设于盒盖上,并与盒盖转动连接;本实用新型具有在翻转盒内放入不同高度的容器时,均能对容器进行稳定、有效地限制,避免其在翻转过程中晃动的效果。

 742
742
 0
0
本实用新型涉及一种二(三氯甲基)碳酸酯光化反应装置,它包括反应釜、气液分离器、一级吸收釜和二级吸收釜,气液分离器入口与反应釜的回流管的出口相连接气液分离器的上部设有与分离气体管的入口相连接的气体出口,下部设有与分离液体管的入口相连接的液体出口,分离液体管的出口与所述反应釜相连通;一级吸收釜的上部设有用以通入所述分离气体管的气体入口,二级吸收釜的上部设有用以通入二级吸收釜进气管的进气口,二级吸收釜进气管与一级吸收釜出气管相连通。本装置能够充分发挥二(三氯甲基)碳酸酯的特性,使固体光气参与的反应能够安全、高效的运行,并减轻了后续废气处理的压力。

 942
942
 0
0
本发明涉及农林秸秆、生活垃圾、危险固废及煤炭为燃料的制气设备领域,特别涉及一步法合成甲烷气化炉,气化炉沿其长度方向依次分为热解区、燃烧区和缺氧区,热解区分为第一热解区和第二热解区,第二热解区靠近燃烧区;第一热解区设置有第一加热装置,第二热解区设置有焦炭排放孔,第二热解区设置有焦炭收集装置;燃烧区设置有输气系统;缺氧区设置有第二加热装置,缺氧区的长度为10?50m。生物质经该气化炉处理后,产出的合成气含有大量甲烷,由分子筛吸附出甲烷成为热值>31.4MJ/m3的天然气;该设备成本低廉,本气化炉在世界上率先将生物质合成天然气能源,同时,炉渣并入焦炭销售,固废零排放。

 756
756
 0
0
本实用新型属于固体废物处理及处置技术领域,涉及垃圾焚烧飞灰等离子体熔融处置系统,包括依次密闭连接的飞灰暂存仓、气力输送系统、球团造粒系统、进料系统、缓冲仓、等离子熔融炉、烟气冷却器、引风机及垃圾焚烧炉,引风机的出气口与垃圾焚烧炉的二次风管道密闭连接;还包括助溶剂仓,助溶剂仓与进料系统密闭连接;飞灰暂存仓用于接收垃圾焚烧炉产生的飞灰,等离子熔融炉的顶部设有等离子炬,等离子熔融炉底部的玻璃体溢流口处设有火焰喷射区。本实用新型将产生的烟气合成气直接极冷,然后二次风管道返回至垃圾焚烧炉,一方面可以借助垃圾焚烧炉除去其中的可燃气体,加强炉内烟气混合和调整炉内温度场。

 845
845
 0
0
本实用新型提供了一种矿山用机架的激光熔覆再制造工装设备,包括底座、底板、旋转变位机、滚轮架、尾座、待修复机架工件、送粉器、光纤激光器、激光熔覆机、卡盘;底座包括旋转变位机、滚轮架和尾座;待修复机架工件通过第一法兰固定安装在旋转变位机上,送粉器固定安装在底座的一侧;光纤激光器固定安装在滚轮架上,激光熔覆机固定安装在待修复机架工件的一侧;卡盘固定安装在尾座上。该设备实现大型零部件的尺寸修复和功能修复,使零部件二次使用及多次重复利用,具有巨大经济价值和研究价值,也会减少废弃产品对环境的污染以及处理工业固体垃圾的费用,同时也能够降低对生产设备的资金投入,提高设备的利用率,从而降低污染,创造更多利润。

 995
995
 0
0
本发明涉及一种铝炭复合促进剂及其制备方法和应用,在剩余污泥的厌氧消化产酸体系中接种实验室自行驯化并处理后的活性污泥,接种量为40%~45%,同时添加利用经过550~600℃煅烧处理氧化铝和100~105℃干燥处理的松木屑为原料以1:2合在650~700℃热解制备的一种新型铝炭复合促进剂。通过添加新型铝炭复合促进剂,剩余污泥厌氧发酵产酸系统中的产酸菌的代谢活性得到一定程度的强化,增强了厌氧发酵产酸的效率。本发明实现固体废物资源化利用的同时有效的提高了污泥厌氧发酵产酸的效果。
中冶有色为您提供最新的江苏常州有色金属固/危废处置技术理论与应用信息,涵盖发明专利、权利要求、说明书、技术领域、背景技术、实用新型内容及具体实施方式等有色技术内容。打造最具专业性的有色金属技术理论与应用平台!
 2025年10月23日 ~ 25日
2025年10月23日 ~ 25日  2025年10月31日 ~ 11月02日
2025年10月31日 ~ 11月02日  2025年11月07日 ~ 09日
2025年11月07日 ~ 09日  2025年11月14日 ~ 16日
2025年11月14日 ~ 16日  2025年11月14日 ~ 16日
2025年11月14日 ~ 16日 
